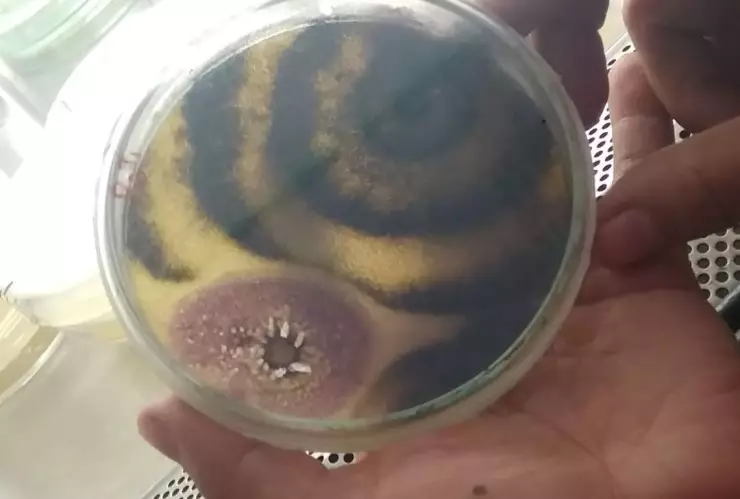
Qué es el patógeno Fusarium graminearum

El ciudadano chino identificado como Yunqing Jian fue detenido por el FBI por intentar introducir el peligroso patógeno biológico “Fusarium graminearum” a los Estados Unidos; un hongo que es considerado un agente terrorista.

Presuntamente, Yunqing Jian realizaba investigaciones en la Universidad de Michigan, pero, según las investigaciones del FBI, también era un hombre que juró lealtad al Partido Comunista Chino y que habría recibido financiamiento de su país para un trabajo sobre este patógeno.
También se detuvo a su pareja, Zunyoung Liu, ambos acusados por delitos de conspiración, contrabando de bienes a Estados Unidos, declaraciones falsas y fraude de visas.
¿Qué es el patógeno Fusarium graminearum?
El FBI lo describió como un hongo que puede causar una enfermedad llamada “Tizón de la espiga”, que afecta a los cultivos de cebada, trigo, maíz y arroz, provocando problemas en los humanos que lo consumen y en el ganado.
El patógeno Fusarium graminearum representa un enorme riesgo para la alimentación y para la economía, ya que ha producido pérdidas millonarias a nivel mundial cada año, afectando directamente a consumidores y productores.
New... I can confirm that the FBI arrested a Chinese national within the United States who allegedly smuggled a dangerous biological pathogen into the country.
— FBI Director Kash Patel (@FBIDirectorKash) June 3, 2025
The individual, Yunqing Jian, is alleged to have smuggled a dangerous fungus called "Fusarium graminearum," which is an…
Daños que provoca el patógeno Fusarium graminearum
De acuerdo con el Sistema Nacional de Vigilancia y Monitoreo de Plagas de Argentina, la afectación puede aplicar para todo tipo de plantas, flores y frutos, incluso raíces, tallos, hojas y semillas.
Asimismo, afecta de diferentes maneras, desde un daño a una planta hasta afectar completamente un cultivo. Por ejemplo, cuando daña una semilla produce la muerte de las plántulas, sin embargo, en una segunda fase, conocida como Gibberella Zeae, afecta a una corona de plantas completa, provocando hongos y matando el cultivo.
Si un humano llega a consumir un producto infectado con Fusarium graminearum podría sufrir infecciones que necesitarán de un tratamiento médico especializado para que no represente un mayor riesgo a su salud .
Más Salud México: Cecilia Fallabrino, CEO de Upax, lidera el proyecto de bienestar en el país
adn40 Siempre Conmigo. Suscríbete a nuestro canal de Telegram y lleva la información en tus manos.